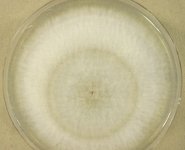

Search Details
| UAMH Number: | 3982 |
|---|---|
| Species Name: | Scedosporium apiospermum |
| Type: | Allescheria boydii |
| Synonyms: | Acremonium suis / Actinomyces albus / Actinomyces tarozzii / Aleurisma apiospermum / Dendrostilbella boydii / Glenospora clapieri / Glenosporopsis clapieri / Indiella americana / Madurella americana / Madurella clapieri / Monosporium apiospermum / Monosporium apiospermum var. peperei / Monosporium sclerotiale / Polycytella hominis / Scedosporium sclerotiale / Streptothrix tarozzii / Trichosporum clapieri |
| Taxonomy: | FUNGI Ascomycota, Sordariomycetes, Microascales, Microascaceae |
| Strain History: | M. Boyd (C.L. Shear) -> CBS 101.22 -> UAMH |
| Substrate: | mycetoma, man | Location: | USA Texas, Galveston (GEO: 29.301,-94.798) |
| Isolator: | M. Boyd (C.L. Shear) |
| Isolation Date: | 1921 |
| Date Received: | 1976-06-23 |
| Characters: | CELLULOLYTIC - // CULTURE CONDITIONS produced Scedosporium anamorph only - // HUMAN/ ANIMAL PATHOGEN - // MOLECULAR SYSTEMATICS Blast match 100% beta tubulin similarity with Pseudallescheria boydii AJ889590 (CBS 101.22T, same strain) - fide UAMH 2012 // MOLECULAR SYSTEMATICS molecular variability in Pseudallescheria boydii - // MOLECULAR SYSTEMATICS phylogeny of Scedosporium, Pseudallescheria and Petriella - Gilgado F, Cano J, Gene J, Sutton DA, Guarro J, J Clin Microbiol 46:766-771, 2008 // MOLECULAR SYSTEMATICS phylogeny of Scedosporium, Pseudallescheria and Petriella - Rainier J, de Hoog GS, Mycol Res 110:151-160, 2006 // MOLECULAR SYSTEMATICS rapid identification of Pseudallescheria and Scedosporium - Lackner M, Najafzadeh MJ, Sun J, Lu Q, Hoog GS, Appl Environ Microbiol 126-133, 2012 (Click for publications citing UAMH 3982) |
| Compounds: | |
| Cross Reference: | CBS 101.22 // DSM 104390 // IHEM 15933 // IMI 015407 // IMI 015407i // JCM 7441 // NCPF 2216 |
| Collections: | Living Strains; Dried Herbarium Material |
| Pathogenic Potential: | Human: yes | Animal: yes | Plant: no |
| Biosafety Risk Group: | RG2 (check the PHAC ePATHogen Risk Group Database for updates) |
| Regulatory Requirements: | Canadian requesters must provide PHAC Pathogen and Toxin License Number (see: https://www.canada.ca/en/public-health/services/laboratory-biosafety-biosecurity/licensing-program.html) prior to shipment. International requesters must provide all legally required importation documentation prior to shipment. This strain is not available for shipment to Cuba, the Democratic People's Republic of Korea, Iran or Syria. Plant pathogenicity status may be verified by using the USDA Agricultural Research Service (ARS) Fungal Database |
| MycoBank ID: | 432048 |
| Sequences: | >UAMH03982_AJ889590_bTub CGAGAAACGGATGCGAGAATATAATTCTTCTGTTCGAGATATTTCTATTTGATGGACAGAGTACTTATCGTATTTTTAGGCAAACCATTTCTGGCGAGCACGGTCTTGATAGCAACGGAGTGTACGGAACCCCCTCATCCCTCCCCCAAATTGCCAGTCACATCGACTGGTGCTGCTCTCACTTTCACGACAGACACTGATTGTCCCTTATACGTCAAAGTTACAATGGCACTTCTGAACTCCAGCTTGAGCGCATGAGCGTTTACTTCAACGAGGTAAGTTTTTGGTTCAAACCACGGGCTGGTTGGTGTGGTGTCATCCAGCCTCCGTTGTTGCGGAAAATACTAACGTATTGGTTACCTCCACATTATAGGCTTCGGGCAACAAATATGTTCCTCGCGCTGTCCTTGTAGATCTCGAGCCCGGTACCATGGACGCCGTCCGTGCTGGTCCCTTCGGCCAACTCTTCCGTCCCGACAACTTCGT >UAMH03982_AJ890121_bTub GGTCAGCTCAACTCTGATCTCCGAAAGATTGCCGTCAACATGGTTCCTTTCCCTCGTCTTCACTTCTTCATGGTCGGCTTTGCCCCGCTTACTAGCCGTGGTGCTCACTCTTTCCGTGCTGTCACCGTGCCCGAGTTGACCCAGCAGATGTTCGATCCCAAGAACATGATGGCCGCCTCCGACTTCCGCAACGGCCGATACCTCACCTGCTCTGCCATCTTGTAAGTTTTATTCTACCCCAAACCCTACGCTCTCTGTCGAGAGTTTCTCTCTCCTTGTGAGGAATCTCTGCTAACAAGGAGTTTTCTCTCTTTCACAGCCGTGGTAAGCTTGCCATGAAGGAGGTCGAGGACCAGATGCGCAACGTCCAGAGCAAGAACTCGTCGTACTTCGTCGAGTGGATCCCCAACAACGTTCAGACCGCTCTTTGCTCTATTCCTCCCCGTGGCCTTAAGATGTCGTCGACCTTCCTGGGTAACTCGACGGCGATCCAGGAGCTCTTCAAGCGTATCGGCGAGC >UAMH03982_UAMH_bTub ATTATTCCCGACGACGCGCGATCGAGAAACGGATGCGAGAATATAATTCTTCTGTTCGAGATATTTCTATTTGATGGACAGAGTACTTATCGTATTTTTAGGCAAACCATTTCTGGCGAGCACGGTCTTGATAGCAACGGAGTGTACGGAACCCCCTCATCCCTCCCCCAAATTGCCAGTCACATCGACTGGTGCTGCTCTCACTTTCACGACAGACACTGATTGTCCCTTATACGTCAAAGTTACAATGGCACTTCTGAACTCCAGCTTGAGCGCATGAGCGTTTACTTCAACGAGGTAAGTTTTTGGTTCAAACCACGGGCTGGTTGGTGTGGTGTCATCCAGCCTCCGTTGTTGCGGAAAATACTAACGTATTGGTTACCTCCACATTATAGGCTTCGGGCAACAAATATGTTCCTCGCGCTGTCCTTGTAGATCTCGAGCCCGGTACCATGGACGCCGTCCGTGCTGGTCCCTTCGGCCAACTCTTCCGTCCCGACAACTTCGTCTTTGGCCAGTCCGGTGCCGGCAACAAC >UAMH03982_AJ890207_CAM TAGACTATTCACTAACAACGCTGTGTGCGTAGGACAAGGATGGTGATGGTGGGTTAAAGATCTACCCTCCCCCAGCCCTCTAATACGCCTTAGTCGGCTTCATTATAGAGTCTCGTCGCCGAACCGGTTTTCTTTCGATCGCTCTTCTAATACGACGACCAGGTCAAATCACGACAAAGGAGCTCGGCACCGTCATGCGCTCCCTCGGCCAGAACCCCTCTGAGTCGGAGCTTCAGGACATGATCAACGAGGTCGACGCCGACAACAACGGAACCATCGACTTCCCCGGTATGCAGCCAGGATGGATGTAATACAGGAAACCAGGAGCTGACTGTTGCTGCAGAGTTCTTGACGATGATGGCGAGGAAAATGAAGGACACCGATTCGGAAGAAGAGATCCGTGAGGCGTTCAAGGTAGGATCGTCGCTGCACTTCTCGCCTCCATCCCGCATCTCTGTTGGCTAATAGACATAGGTCTTCGACCGTGATAACAATGGCTTCATCTCGGCTGCCGAACTTCGCCATGTCATGACTTCAATCGGCGAAAAGCTAACCGACGATGAGGTCGACGAGATGATTCGTGAGGCTGACCAAGACGGCGATGGAAGGATTGACTGTTCGTATATCCCTTTCTCAGCCTGGTCTGGAAGTTGC >UAMH03982_AF027669_LSU GTCGAGTTGTTTGGGAATGCTGCTCAAAATGGGAGGTAAACCCCTTCTAAAGCTAAATACTGGCCAGAGACCGATAGCGCACAAGTAGAGTGATCGAAAGATGAAAAGCACTTTGAAAAGAGAGTTAAACAGCACGTGAAATTGTTGAAAGGGAAGCGCTTGCGACCAGACTTGTGCCCGTCGAATCAGCCGCCGCTCGTCGGCGGCGCACTTCGGCGGGCTCAGGCCAGCATCAGTTCGCTGCAGGGGGAGAAAGGCGATGGGAATGTGGCTCTTCGGAGTGTTATAGCCCGCCGCGCAATACCCCTCGGCGGACTGAGGACCGCGCATCTGCAAGGATGCTGGCGTAATGGTCGTCAGCGACCCGTCTTGAAACAC >UAMH03982_AJ888435_SSU-LSU ACAGAGTTACTACTCCAAACCCATTGTGAACCTTACCTATGTTCTGTTGCCTCGGCGGCGTGGTCAGCGCCCCCCTCTGAAAAGAGGACGATGCCCTCCCGCCGGCAGCACCAAACTCTTTGAATTTTACAGCGGATTACAGTTCTGATTTGAAAACAAAAAACAAGTTAAAACTTTCAACAACGGATCTCTTGGTTCTGGCATCGATGAAGAACGCAGCGAAATGCGATAAGTAATGTGAATTGCAGAATTCAGTGAATCATCGAATCTTTGAACGCACATTGCGCCCGGCAGTAATCTGCCGGGCATGCCTGTCCGAGCGTCATTTCAACCCTCGAACCTCCGTTTCCTCAGGGAAGCTCAGGGTCGGTGTTGGGGCGCTACGGCGAGTCTTCGCGACCCTCCGTAGGCCCTGAAATACAGTGGCGGTCCCGCCGCGGTTGCCTTCTGCGTAGTAAGTCTCTTTTGCAAGCTCGCATTGGGTCCCGGCGGAGGCCTGCCGTCAAACCACCTATAACTCCAGATGGTT >UAMH03982_AY228111_SSU-LSU TTTGTACACACCGCCCGTCGCTACTACCGATTGAATGGCTCAGTGAGGCTCCGGACTGGCCCAGAGAGGTGGGCAACTNCCACTCAGGGCCGGAAAGTTGTCCAAACTCGGTCATTTAGAGGAAGTAAAAGTCGTAACAAGGTCTCCGTTGGTGAACCAGCGGAGGGATCATTACAGAGTTACTACTCCAAACCCATTGTGAACCTTACCTATGTTCTGTTGCCTCGGCGGCGTGGTCAGCGCCCCCCTCTGAAAAGAGGACGATGCCCTCCCGCCGGCAGCACCAAACTCTTTGAATTTTACAGCGGATTACAGTTCTGATTTGAAAACAAAAANNNNTTAAACNTTCAACAACGGATCTCNTGGNTCTGGCATCGATGAAGAAGCAGCGAAANGCGATAAGTAATGTGAATTGCAGAATTCAGTGAATCATCGAATCTTTGAACGCACATTGNNNCGGCAGTAATCTGCCGGCATGCCTGTCCGAGCGTCATTTCAACCCTCGAACCTCCGTTTCCTCAGGGAAGCTCAGGGTCGGTGTTGGGGCGCTACGGCGAGTCTTCGCGACCCTCCGTAGGCCCTGAAATACAGTGGCGGTCCCGCCGCGGTTGCCTTCTGCGTAGTAAGTCTCTTTTGCAAGCTCGCATTGGGTCCCGGCGGAGGCCTGCCGTCAAACCACCTATAACTCCAGATGGTT |
IMAGES: